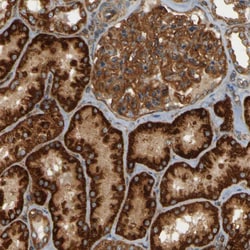
Invitrogen CSP alpha Polyclonal Antibody 100 &mu;L; Unconjugated:Antibodies,

missing translation for 'onlineSavingsMsg'
Learn More
Learn More
Invitrogen™ CSP alpha Polyclonal Antibody
Rabbit Polyclonal Antibody
Brand: Invitrogen™ PA553025
This item is not returnable.
View return policy
Description
Immunogen sequence: MADQRQRSLS TSGESLYHVL GLDKNATSDD IKKSYRKLAL KYHPDKNPDN PEAADKFKEI NNAHAILTDA T Highest antigen sequence identity to the following orthologs: Mouse - 100%, Rat - 100%.
Cysteine string protein alpha (CSPalpha) is a synaptic vesicle protein that contains a DNA-J domain characteristic of Hsp40 chaperones. Cysteine-string proteins are membrane-bound proteins associated primarily with nerve endings and synaptic vesicles in the brain. These proteins play an important role in presynaptic function and may be involved in calcium-dependent neurotransmitter release. CSP proteins may act as presynaptic chaperones that assist in maintaining synaptic function.
Specifications
| CSP alpha | |
| Polyclonal | |
| Unconjugated | |
| Dnajc5 | |
| 2610314I24Rik; AU018536; Ceroid-lipofuscinosis neuronal protein 4; CLN4; CLN4B; Csp; CSP alpha; cysteine string protein; cysteine string protein alpha; DnaJ (Hsp40) homolog, subfamily C, member 5; DnaJ heat shock protein family (Hsp40) member C5; dnaJ homolog subfamily C member 5; Dnajc5; DNAJC5A; mir-941-2; mir-941-3; mir-941-4; mir-941-5; NCL | |
| Rabbit | |
| Antigen affinity chromatography | |
| RUO | |
| 80331 | |
| Store at 4°C short term. For long term storage, store at -20°C, avoiding freeze/thaw cycles. | |
| Liquid |
| Immunohistochemistry (Paraffin) | |
| 0.1 mg/mL | |
| PBS with 40% glycerol and 0.02% sodium azide; pH 7.2 | |
| Q9H3Z4 | |
| Dnajc5 | |
| Recombinant protein corresponding to Human DNAJC5. Recombinant protein control fragment (Product #RP-90032). | |
| 100 μL | |
| Primary | |
| Human | |
| Antibody | |
| IgG |
Product Content Correction
Your input is important to us. Please complete this form to provide feedback related to the content on this product.
Product Title
Spot an opportunity for improvement?Share a Content Correction